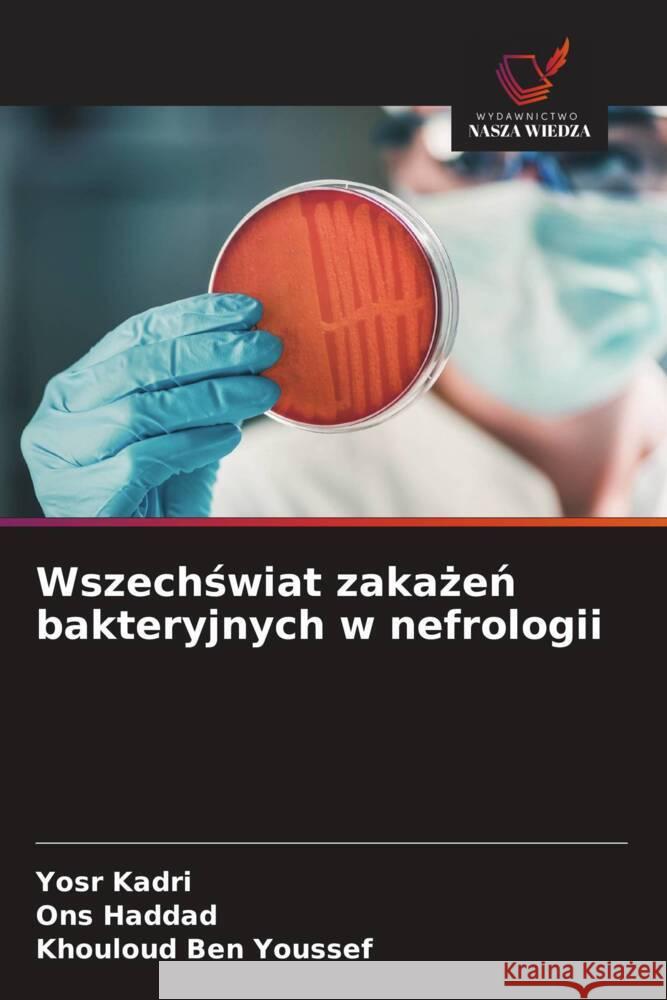
Wszechswiat zakazen bakteryjnych w nefrologii Kadri, Yosr, Haddad, Ons, Ben Youssef, Khouloud 9786208318505 Wydawnictwo Nasza Wiedza - książka

Wszechswiat zakazen bakteryjnych w nefrologii » książka
topmenu
Wszechswiat zakazen bakteryjnych w nefrologii
ISBN-13: 9786208318505 / Polski / Miękka / 2024 / 60 str.
Kategorie BISAC:
Wydawca:
Wydawnictwo Nasza Wiedza
Język:
Polski
ISBN-13:
9786208318505
Rok wydania:
2024
Ilość stron:
60
Wymiary:
22.0 x 15.0
Oprawa:
Miękka